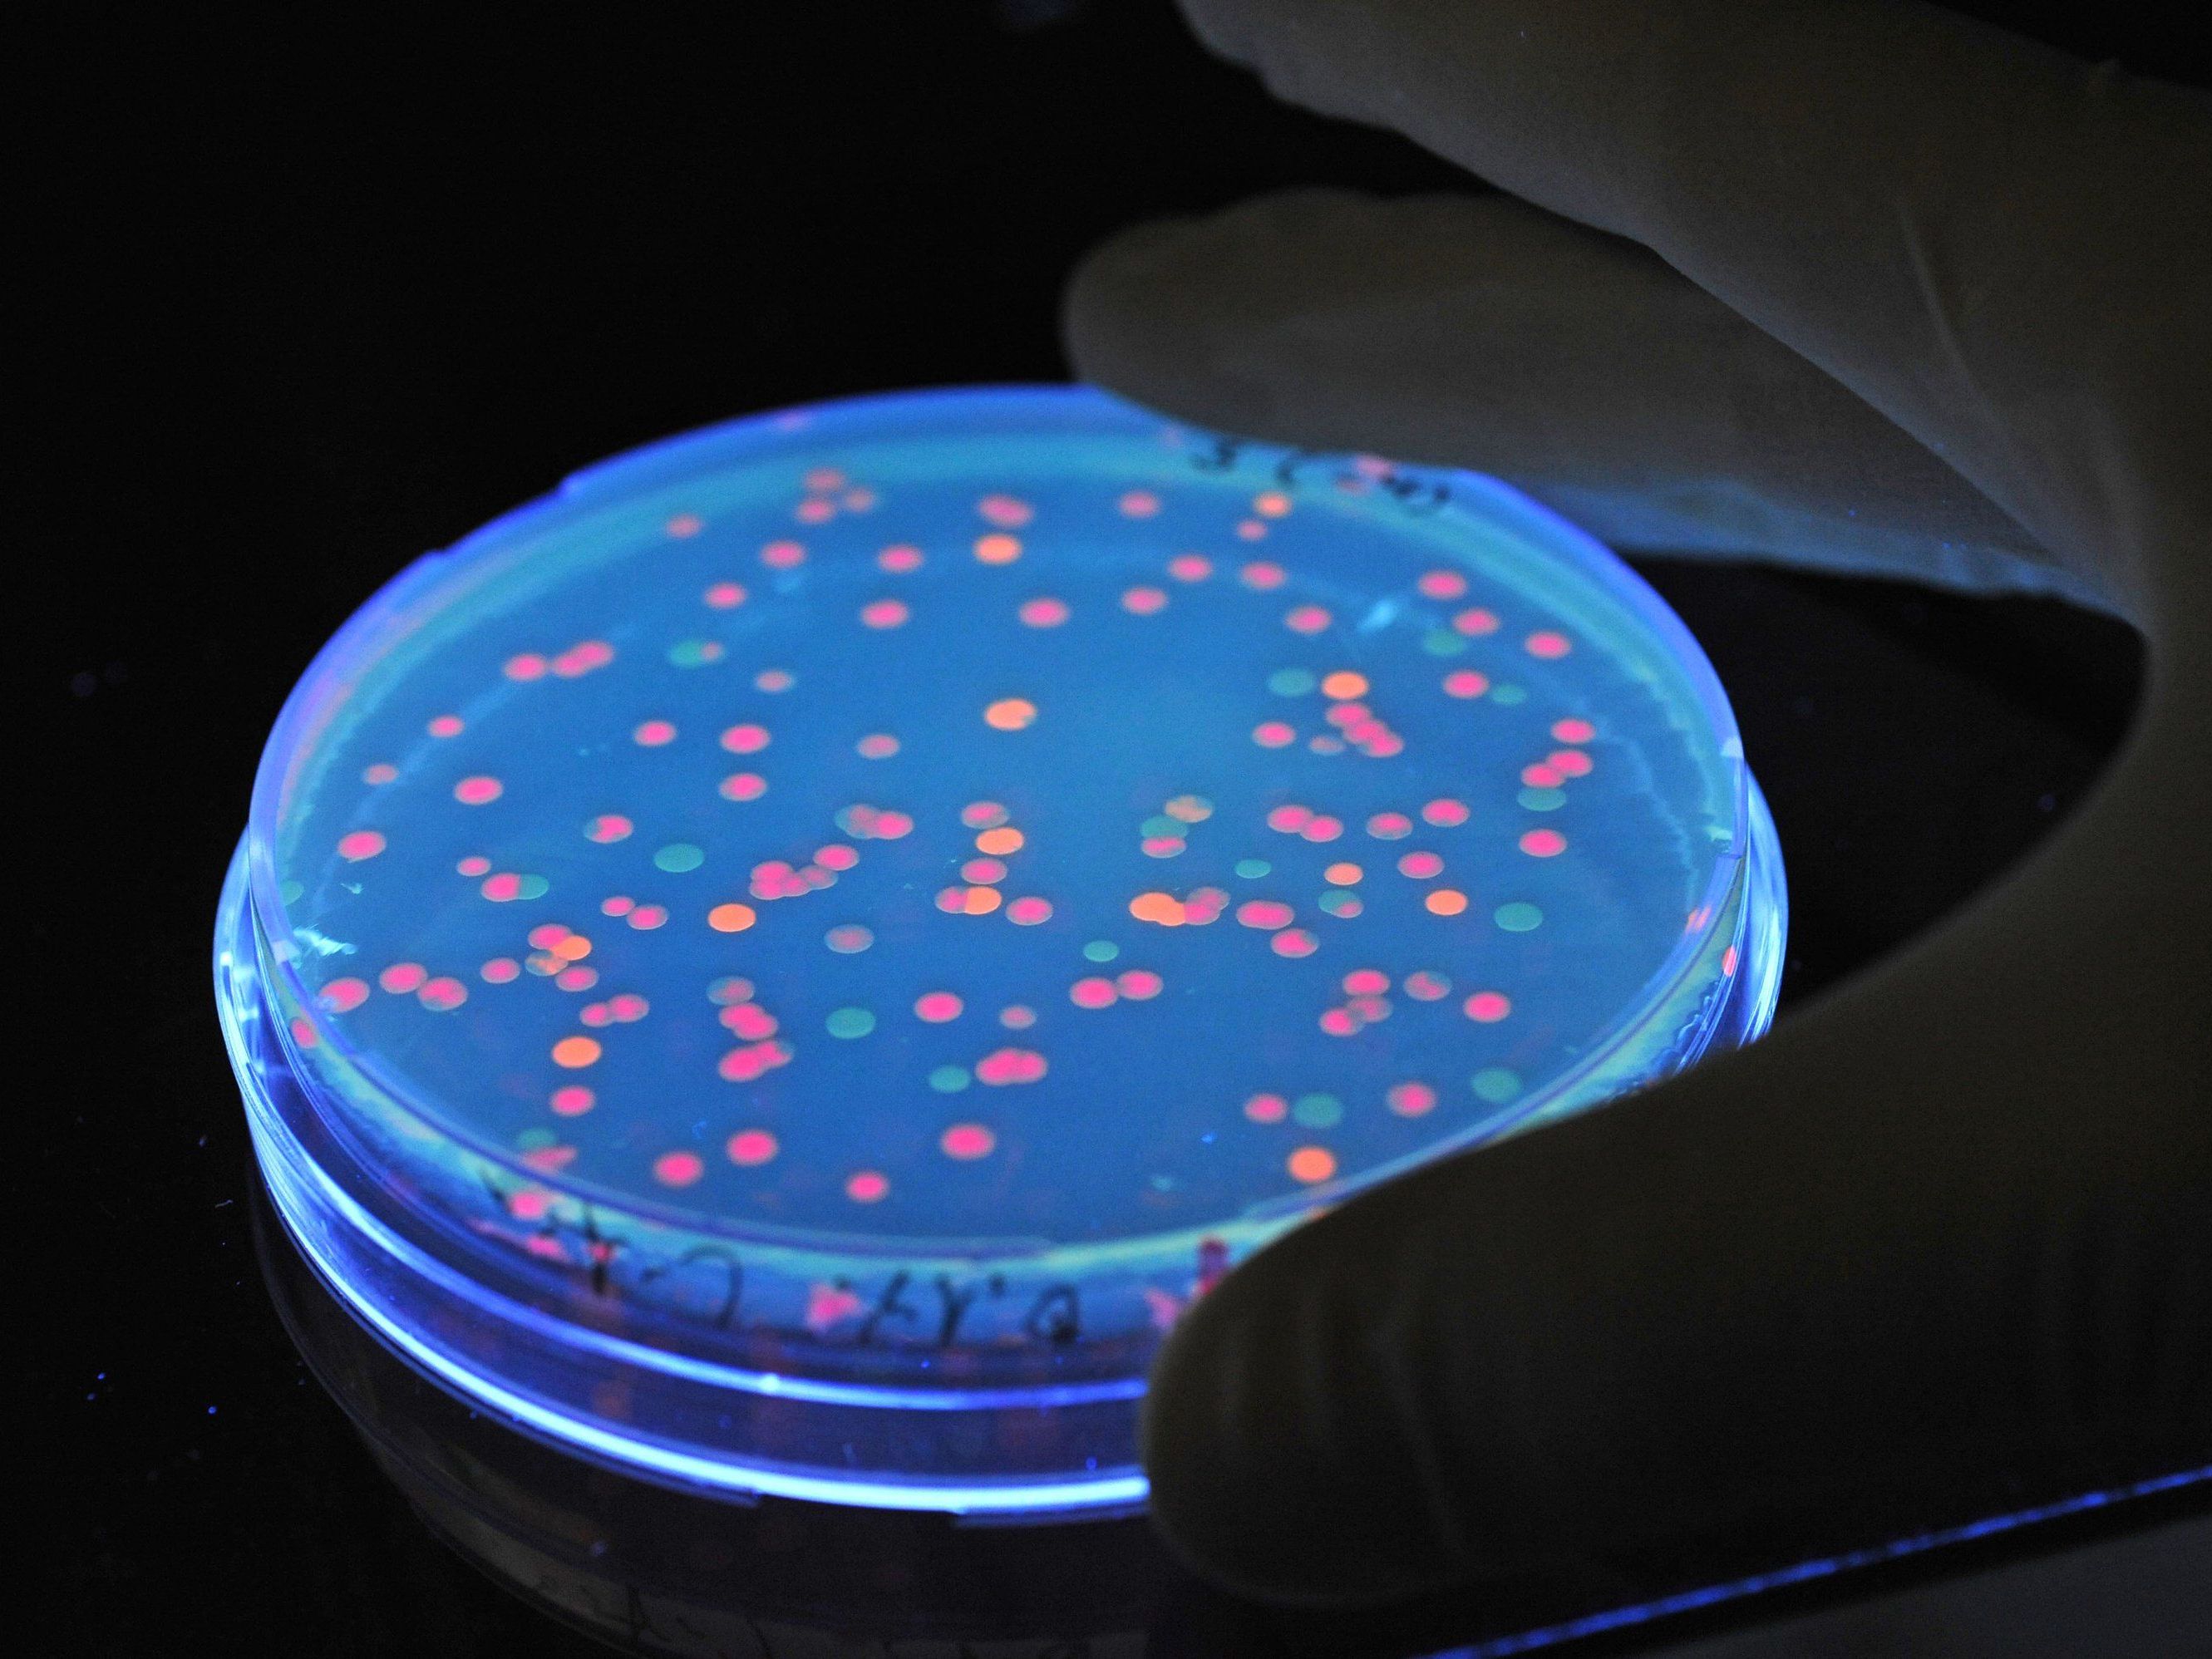

Salmonellen-Ausbruch durch Eier aus Bayern: Tiroler tot
“Es wird geprüft, ob die Firma gefährliche Lebensmittel in den Verkehr gebracht hat”, sagte der Regensburger Oberstaatsanwalt Theo Ziegler am Donnerstag. Er bestätigte entsprechende Berichte des Bayerischen Rundfunks und der “Süddeutschen Zeitung”. Derzeit lägen keine gesicherten Erkenntnisse vor, dass durch die Eier der niederbayerischen Firma Menschen zu Schaden gekommen seien, betonte Ziegler. Sollte sich der Verdacht jedoch erhärten, würden die Ermittlungen auf fahrlässige Tötung ausgeweitet. Am Dienstag hatten Ermittler Geschäftsräume des Unternehmens durchsucht und Unterlagen sichergestellt. Von der Firma Bayern-Ei gab es zunächst keine Stellungnahme.
Österreich: 151 Menschen betroffen
In Österreich waren 151 Menschen von dem Salmonellenausbruch (S. Enteritidis PT14b) betroffen, berichtete die Agentur für Gesundheit und Ernährungssicherheit (AGES) auf APA-Nachfrage. Bis auf das Burgenland und in Vorarlberg gab es in jedem Bundesland Fälle, die meisten in Tirol (69 Fälle). Der Großteil der Fälle wurde durch die Konsumation von Speisen, die in einer Großküche eines sozialen Dienstes zubereitet wurden, verursacht – davon betroffen war auch der 75-Jährige, der in einem Altersheim lebte. “Die Recherche über ein europaweites Netzwerk (EPIS FWD) ergab, dass in Frankreich, Deutschland, Luxemburg, dem Vereinigten Königreich und den Niederlanden weitere Fälle mit demselben Ausbruchstamm auftraten”, berichtete die AGES.
Behörden reagierten zögerlich
Laut den Berichten von Bayerischem Rundfunk und “Süddeutscher Zeitung” gingen im Juli vergangenen Jahres Salmonellose-Warnungen aus dem Ausland beim Bayerischen Landesamt für Gesundheit und Lebensmittelsicherheit (LGL) ein. Die Behörden sollen zögerlich reagiert haben. Proben seien teilweise erst nach mehreren Wochen an die zuständigen Labors geschickt worden. Mutmaßlich verseuchte Eier sollen zunächst nicht zurückgerufen worden sein.
Das LGL wies die Vorwürfe zurück und betonte: Für eine öffentliche Warnung vor Eiern aus dem betroffenen Betrieb habe es in Bayern zu keinem Zeitpunkt die fachlichen und rechtlichen Voraussetzungen gegeben. Eine öffentliche Warnung in Bayern setze eine andauernde Gesundheitsgefahr für bayerische Verbraucher voraus. Dazu müssten gesundheitsgefährdende Lebensmittel in Bayern in den Verkehr gelangt sein und sich noch beim Verbraucher befinden. Dies sei aber nach den Ermittlungserkenntnissen der bayerischen Behörden nicht der Fall gewesen, erläuterte eine Sprecherin des LGL.
(APA)
Du hast einen Hinweis für uns? Oder einen Insider-Tipp, was bei dir in der Gegend gerade passiert? Dann melde dich bei uns, damit wir darüber berichten können.
Wir gehen allen Hinweisen nach, die wir erhalten. Und damit wir schon einen Vorgeschmack und einen guten Überblick bekommen, freuen wir uns über Fotos, Videos oder Texte. Einfach das Formular unten ausfüllen und schon landet dein Tipp bei uns in der Redaktion.
Alternativ kannst du uns direkt über WhatsApp kontaktieren: Zum WhatsApp Chat
Herzlichen Dank für deine Zusendung.



